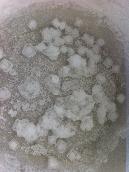

CRISTALIZACIONES
febrero - Ciencias Naturales
Los alumnos/as de 3º ESO realizaron estas fantásticas cristalizaciones en las que se puede ver el maravilloso orden de la materia cristalina. Una simple disolución de sal en agua y al cabo de los días la evaporación hace el resto...
Imágenes
| «« | « | Junio 2026 | » | »» | ||
| L | M | Mi | J | V | S | D |
| 1 | 2 | 3 | 4 | 5 | 6 | 7 |
| 8 | 9 | 10 | 11 | 12 | 13 | 14 |
| 15 | 16 | 17 | 18 | 19 | 20 | 21 |
| 22 | 23 | 24 | 25 | 26 | 27 | 28 |
| 29 | 30 | |||||